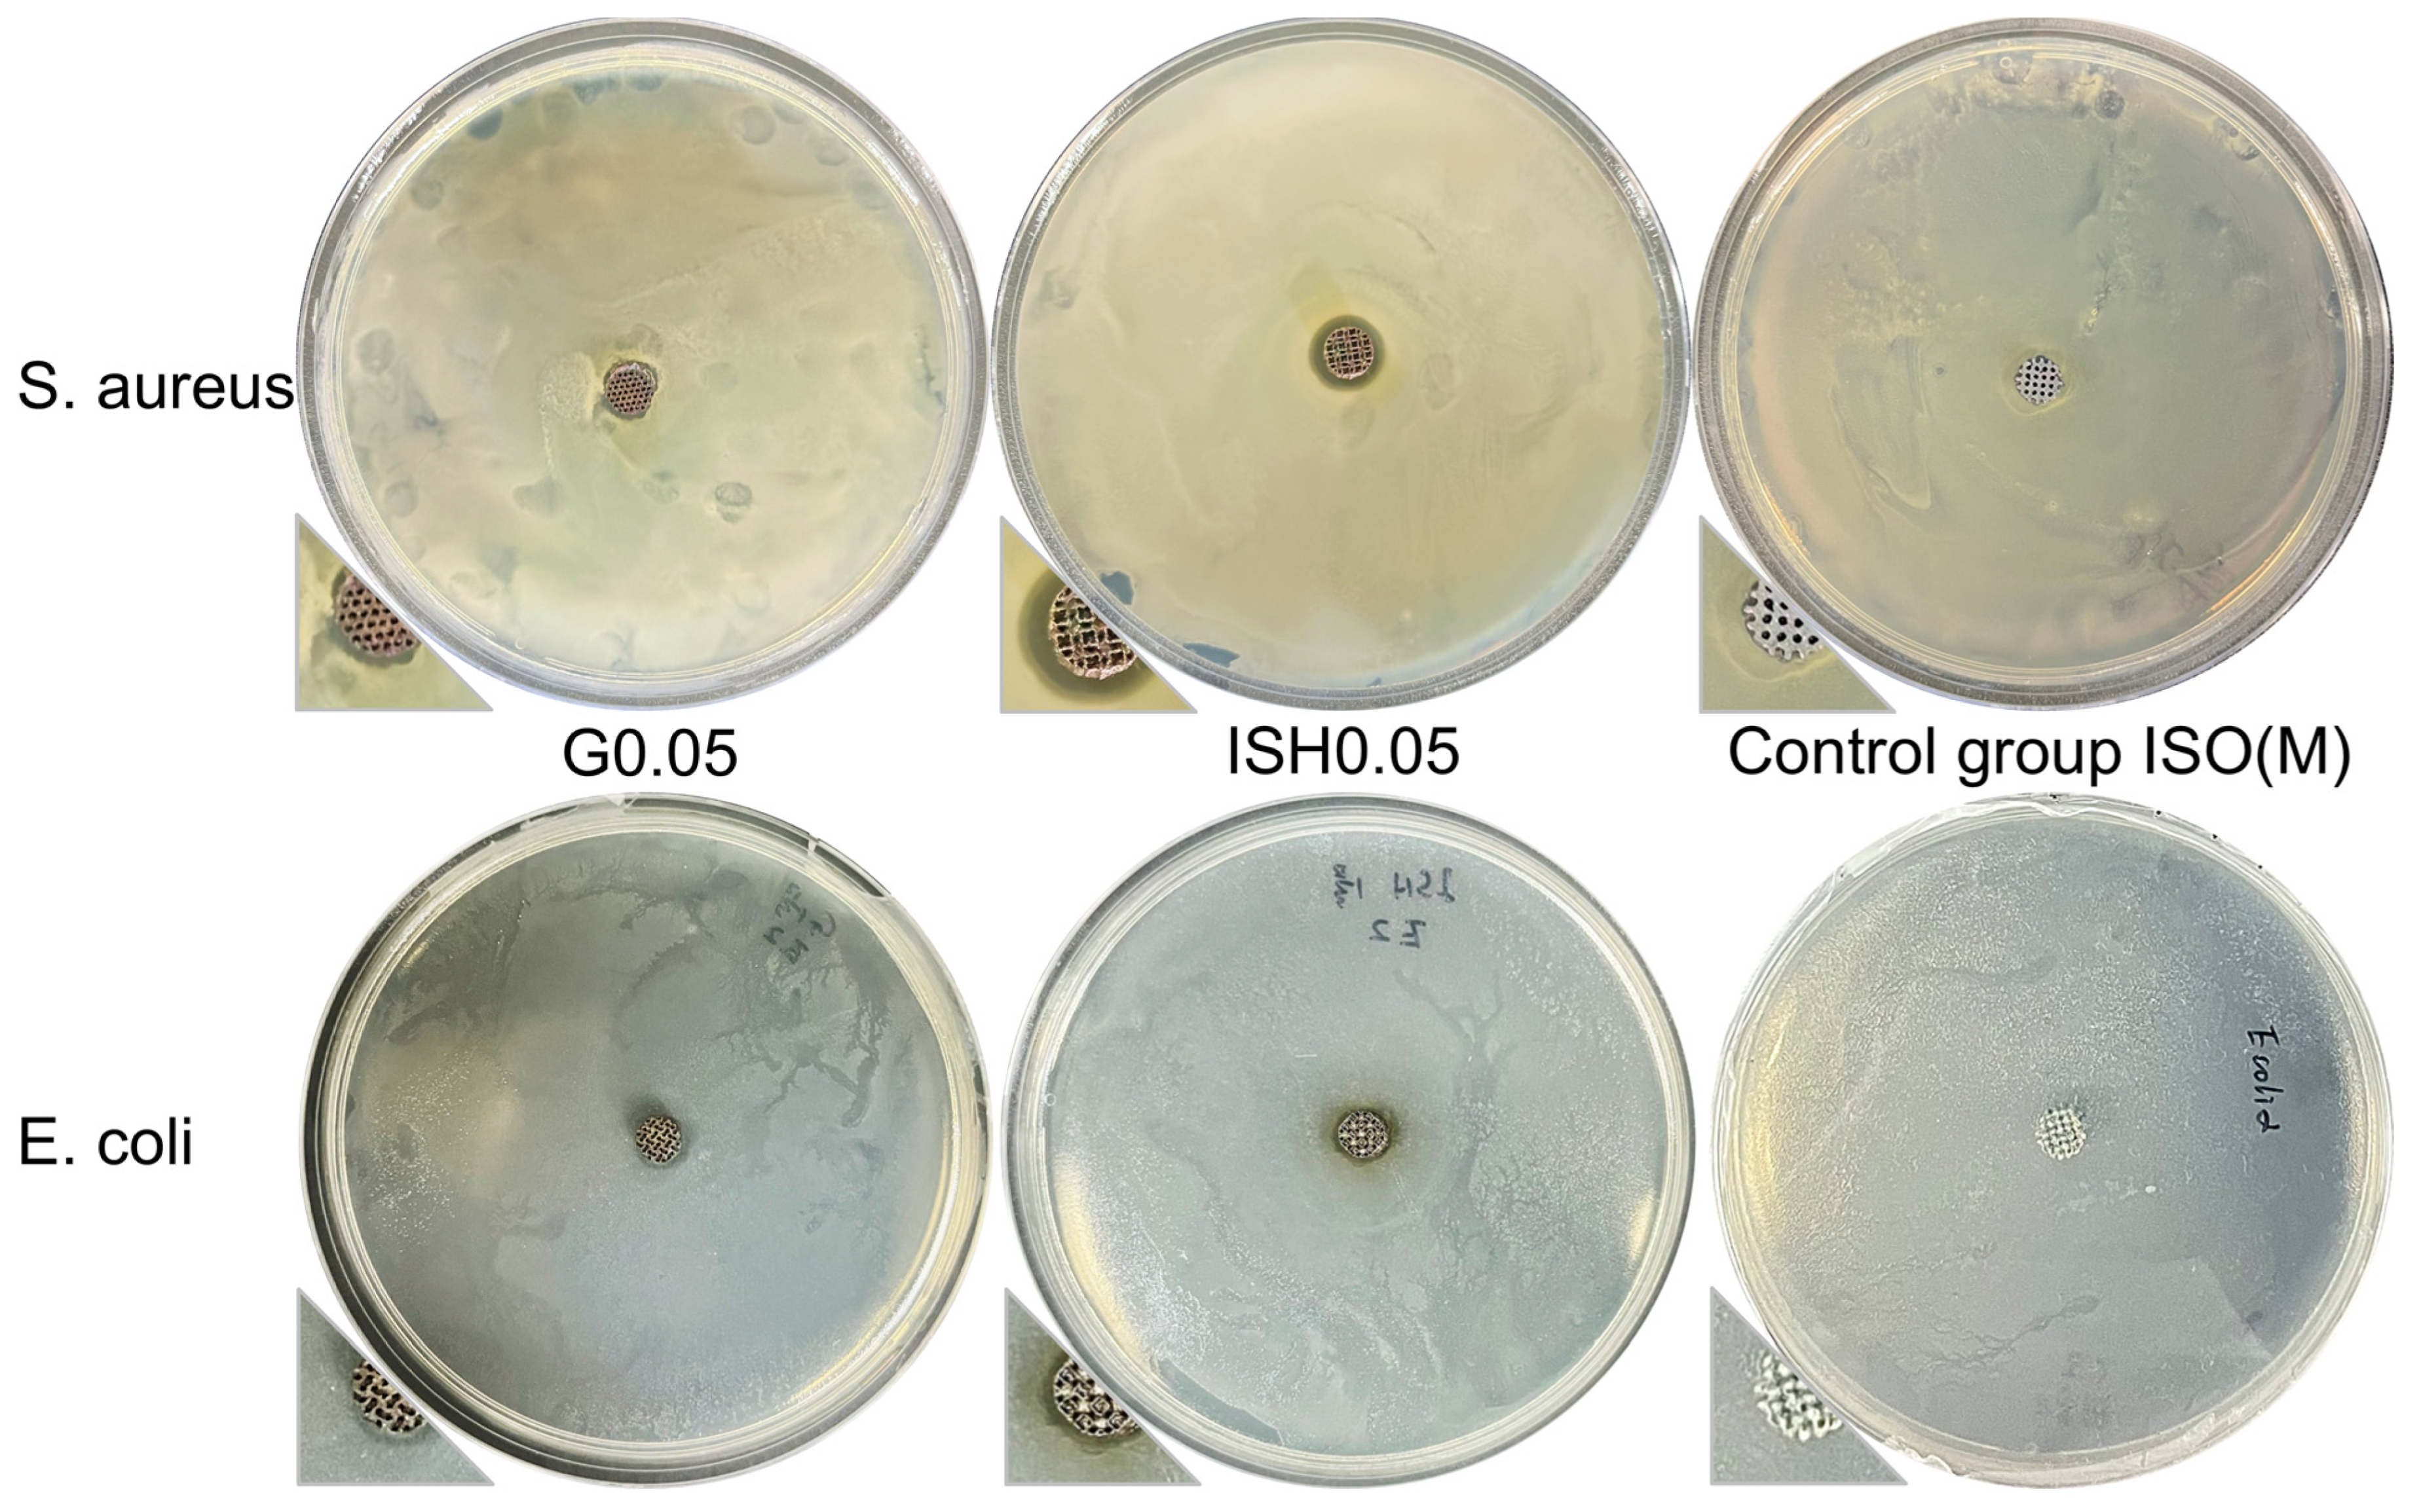
Metals 15 00355 g014

Abstract
Ti and Ti alloys are being widely used as bone tissue repair materials. Progress on mechanical properties and bio-functionality is required for their applications due to the large difference in elastic modulus between bone and Ti implants and the fact that the Ti materials themselves are biologically inert. In this work, a low-modulus, β-phase Ti-15Mo alloy based on a triply periodical minimal surfaces (TPMS) structure was fabricated using a Powder Bed Fusion-Laser Beam (PBF-LB) under optimized printing parameters into implant samples with controllable porous structures. The selection of TPMS, lattice unit cell size, and relative density was based on a combination of mechanical properties and cytocompatibility. Surface modifications were used to further impart antibacterial, antioxidant, and osteogenesis properties to the implants. Broad-spectrum antibacterial Ag, antioxidant tannic acid (TA), and highly stable fluorinated hydroxyapatite ((F)HA) were applied as an advanced coating on a microporous TiO2 surface modification layer formed by micro-arc oxidation. Ultimately, porous Ti-15Mo implant samples with a biofunctional coating were obtained with Young’s modulus 15–50 GPa, a yield strength of approximately 100 MPa, and good cytocompatibility, hemocompatibility, and bactericidal effects. This study provides a systematic scheme for the preparation and surface modification of β Ti alloy implants for subsequent studies.
1. Introduction
Titanium (Ti) alloys have excellent biomechanical properties and good biocompatibility and are commonly used as hard tissue grafting materials in medical applications. However, the widely used Ti-6Al-4V alloy and commercially pure (CP) Ti have a stress shielding effect due to the mismatch between their elastic modulus of approximately 105–110 GPa and the bone tissue [1,2,3], which can lead to degradation of the original bone tissue and ultimately to implant failure [4]. Moreover, Ti alloys are biologically inert materials and have difficulty forming strong biological bonds with bone tissue. β-phase Ti alloys, on the other hand, are considered to have great potential to become a new generation of Ti alloys for medical applications due to their low modulus of elasticity, high biocompatibility, and corrosion resistance [5], of which the Ti-Mo family is represented by Ti-15Mo, with an elasticity modulus of 75–80 GPa [6,7,8].
The elastic modulus of the biomaterial is key to the force distribution and stress shielding effect of the implant, and in this regard, porous structures are ideal candidates. Compared to dense materials, porous structures greatly reduce stiffness [9,10] and are particularly suitable for applications in β Ti alloys where the modulus still does not match the modulus of human bone (0.022 to 21.8 GPa) [11]. At the same time, porous structures with through holes also facilitate biological cell behavior, such as cell adhesion, proliferation, and bone tissue regeneration [12,13,14,15], which can lead to greater biological bonding between implant and tissue, thus enhancing implant fixation and improving implant success. Additive manufacturing techniques, such as Laser Based Powder Bed Fusion (PBF-LB) are considered to be one of the most favorable methods for the fabrication of complex porous structures for artificial bone implants, as they are capable of producing alloy components with complex internal structures [16,17,18]. Compared to conventional subtractive manufacturing methods, PBF-LB offers the flexibility to modulate the porosity of porous alloys and to produce complex shapes, facilitating the creation of customized porous bone implant scaffolds.
In fact, the inner surface of real bone is mostly composed of irregular surfaces, and studies have shown that the surface curvature of the scaffold microstructure has an important impact on the regeneration process of bone tissue [19,20]. Bidan et al. [21,22] proposed that the average curvature of the structural surface in trabecular bone is approximately 0, which has drawn attention to the submicroscopic structure of the bone and the method of constructing porous bone implant scaffolds with minimal curved surfaces. Unlike conventional microstructures in porous scaffold designs, since the curvature on triply periodical minimal surfaces (TPMS) is 0 everywhere, the local surface energy of TPMS bone scaffolds is minimal [23], and the thermodynamic state is stable [20]. An implant of TPMS lattice has good connectivity, relatively high specific surface area, and relatively tortuous internal channels. Studies have shown that when the porosity of the implant of TPMS lattice is similar to that of trabecular bone, the structure has a higher yield stress and a lower elastic modulus [24]. In addition, functional gradient-type scaffolds with morphological features such as variable density can be generated by adjusting the surface equations [25,26]. The best pore size, however, has been determined differently by various studies. For instance, in a biomaterial structure, pores between 100 and 350 μm were deemed to be appropriate for cell colonization and vascularization and aiding bone tissue penetration [27]. Capillary growth will be encouraged in the bone scaffold by pores larger than 140 μm [28], and cell proliferation will be aided by pores larger than 300 μm [14]. According to research by Murphy et al. [29], bone production peaked at 325 μm pore size. When the pore size was between 300 and 1200 μm, bone production did not differ noticeably, as demonstrated by Hollister et al. [30]. Moreover, rats with femoral defects experienced a positive healing effect through a cylindrical bone scaffold of 80% porosity with pore sizes between 400 and 600 μm [31].
In addition to modification of the substrate of Ti alloy implants, surface modification and loading with various functional physiochemical coatings to improve osseointegration has been the focus of research [3,32,33]. Ti surface roughening and micro-nano treatment can effectively improve the bonding performance with bone tissue [34,35]. Micro-arc Oxidation (MAO) is a new modification technique based on the anodic oxidation of valve metals (Al, Ti, Ag, Nb, etc.) to produce a layer of porous TiO2 ceramics grown in situ on the surface [35,36,37]. It uses a high working voltage and introduces the working area into the high voltage discharge zone, instead of the Faraday zone of anodic oxidation [38]. The TiO2 ceramic layer, which is firmly bonded to the substrate, can be modified by adjusting the power supply parameters and electrolyte formulation to change the hardness, wear resistance, and roughness of the Ti alloy surface, thus improving the bonding properties to the bone tissue [39,40].
To prevent bacterial adhesion, antibacterial bioactive coatings can be prepared on the surface of Ti implants. Nano Ag has broad-spectrum antimicrobial properties, but it has a dose-dependent cytotoxicity, so the appropriate concentration is important for striking a balance between biocompatibility and antimicrobial properties. Hydroxyapatite (HA) has good bioactivity and osteogenic properties and can be compounded with various antimicrobial agents. Studies have shown that the doping of HA with F can improve its stability [41,42,43,44], and the corrosion resistance of fluoride-hydroxyapatite ((F)HA) increases with increasing F content [45]. Cellular experiments have shown that F-doping can improve the biological properties of HA [46,47], and a small amount of F ions can improve osteoblast activity [48] and promote cell proliferation [45]. Coating Ag nanoparticles with HA reduces the risk to human tissues while maintaining the good antimicrobial properties of Ag. Hence, in order to further improve the osteogenicity on a cell adhesion scale and make the bonding of HA and Ti stronger, microporous TiO2 prepared by MAO is designed as an intermediate layer between Ti alloy and coating. In the presence of inflammation or certain pathologies (e.g., diabetes), excessive production and accumulation of reactive oxygen species (ROS) can trigger an oxidative stress response that can affect the biological performance of surrounding osteoblasts, which in turn can lead to deterioration and failure of the implant. Tannic acid (TA) with many pyrogallol groups as part of a composite coating can increase the antibacterial and antioxidant capacity of the specimen, which has been used in the dental field [49,50,51].
In this paper, pre-alloyed Ti-15Mo powder was used, and TPMS lattices were designed and selected with full consideration of the mechanical properties and biocompatibility. After PBF-LB preparation and annealing, the microstructure and mechanical properties of the samples were characterized. Samples with superior properties were selected for surface modification to enhance bio-functionality. In order to impart antioxidant properties to Ti alloy implants, this study prepared a layer of TA-Ca complex on the surface of MAO produced microporous TiO2 as a calcium site for (F)HA formation using strongly reducing TA as an antioxidant, and then induced the formation of (F)HA coating by a hydrothermal method; the prepared coating is expected to have good antioxidant activity and biological properties. Considering the antimicrobial and anti-infective capacity, Ag nanoparticles are covered by (F)HA in the composite coating to create a slow release effect.
2. Materials and Methods
2.1. Raw Materials
The Ti-15Mo powder (Figure 1) used in this experiment was purchased from Northwest Institute for Non-ferrous Metal Research (Xi’an, China) and produced by the gas atomization method. A laser particle size analyzer was used to assess the particle size, and the results revealed that the particle size was Dv (50) = 38.4 μm. The as-cast sample used for comparison was taken from the powder supplier (Keruikerui Co., Ltd., Wuxi, China).
Figure 1.
Powder size distribution of pre-alloyed Ti-15Mo.
2.2. Lattices Design and Samples Design
Uniform TPMS structures were designed by MSLattice 1.0 [52], a software based on MATLAB R2020a, applying the mathematical description of those surfaces to produce 3D models. The nodal coordinates that represent a minimal surface have been described using a number of different mathematical techniques. The level-set approximation strategy, the most straightforward and popular technique, uses a set of trigonometric functions satisfying F(x,y,z) = const (constant for an iso-surface). The following are the level-set equations describing the minimal surfaces chosen in this work. Figure 2a represents the design and preparation process of the porous Ti-15Mo lattices. Both solid and sheet lattices derived from the surfaces are shown. Gyroid (G), sheet IWP (ISH), and solid IWP (ISO) structures were chosen because studies [53,54] have shown that they use less material and have better mechanical properties under the same unit cell size.
where X = 2απx, Y = 2βπy, Z = 2πγz, in which α, β, and γ are constants associated with the lattice unit cell parameters in the x, y, and z directions, respectively.
Figure 2.
Scheme diagram of (a) sample fabrication process; (b) the surface modification process; (c) the in vitro biocompatibility and biomedical function tests.
When the above unit cell size was set to 1.5 mm and the relative density (RD) was set to 30–40% (Figure 3a), the lattice derived using MSLattice presented a suitable layer thickness and pore size. As introduced before, these lattices facilitate cell growth with the desired strength at lower densities and lower moduli, while being within the limits of the MSLattice design and PBF-LB fabrication. Samples of various shapes for testing mechanical properties and performing in vitro experiments were designed after determining the lattices. Figure 3b,c show two sets of the designs of samples. The samples are named by lattices and densities for G30, G35, G40; ISH30, ISH35, ISH40; ISO30, ISO35, and ISO40, respectively. It needs to be mentioned that based on the NumPy library, which supports complex computations in multiple dimensions, some programs were written in Python 3.8.8 to parse .stl files to calculate the surface area of the .stl models by summing up all polygonal regions of the mesh.
Figure 3.
The models designed by MSLattice and the formability of printed samples: (a) the optimized printing and designed parameters; (b) the models of tensile bars; (c) the cylindric samples for in vitro tests are shown with dimensions; (d) the forming accuracy of as-printed G, ISH and ISO samples.
2.3. PBF-LB Processing and Process Optimization
The PBF-LB printer used in the experiments was an EOS M290 3D printer (EOS GmbH Electro Optical Systems, Munich, Germany) equipped with a 400 W fiber laser (1064 nm). Its spot diameter is about 70 μm, and it can prepare materials in the range of 250 × 250 × 325 mm3 in a high-purity argon atmosphere. The interlayer rotation angle was 67°, and the scanning strategy was Chess Scan. The volume energy density (VED) was used for understanding the laser energy input. Equation (3) defines the calculation of this parameter [55]:
where PL is laser power, vs is scanning speed, hs is scanning pitch, and tl is single-layer layer thickness.
The layer thickness was set to 50 μm according to the average powder particle size. After multiple trials, the optimum sample relative density of 99.3% was determined when printing a dense bulk sample utilizing the drainage method. At this moment, the corresponding VED = 100 J/mm3, and the lattice’s VED was designed for 40% of it. The optimized printing parameters are shown in Figure 3a.
All as-printed samples were annealed in a vacuum heat treatment furnace (MH(BR)-669-HV, FULCRUM, Shanghai, China) at a rate of 5 °C/min to 500 °C, held for 3 h [56,57]. After the samples were naturally cooled to 300 °C in the furnace, Ar was passed through the furnace to reduce to room temperature.
2.4. Microstructural Analysis
An optical metallographic microscope (OM) (Zeiss, Oberkochen, Germany) was used for the metallographic observation, which also required polishing and etching before observation. Afterwards, the alloy surface was etched using Kroll solution (3 mL HF:5 mL HNO3:100 mL H2O). The samples were subsequently ultrasonically cleaned with anhydrous alcohol and dried completely before further study by microscopy.
For the X-ray diffractometer (XRD, SmartLab, Rigaku, Tokyo, Japan) analysis, the 2θ angle range was set to 30–80°, the step size was set to 0.02°, and the test speed was set to 6°/min. The grazing incidence small-angle X-ray scattering (GISAXS) patterns were obtained using the same X-ray diffractometer and 2 h scanning from 10–30°. The morphology of the unit cells of the printed samples and sample microstructures was examined using the secondary electron mode of a TESCAN MIRA3 (TESCAN, Brno, Czech Republic), HITACHI SU8230 (Hitachi High-Tech Corporation, Tokyo, Japan), and Zeiss Merlin (Carl Zeiss AG, Oberkochen, Germany) scanning electron microscope (SEM, accelerating voltage 5 kV, operating current 100 pA). The energy-dispersive X-ray spectroscopy (EDS) mode (accelerating voltage 25 kV, operating current 2 nA) was used to analyze the surface chemical composition.
The electron backscatter diffraction (EBSD) accessory in the Zeiss Merlin SEM characterizes the phase distribution, grain size, and grain boundary information at a 20 kV voltage, 5000 pA current, and 15 mm working distance. The test data were analyzed by the OIM Analysis 7 software 7.3.1.1.
2.5. Mechanical Property Testing
With the use of the HX-1000TM/LCD automatic turret microhardness tester (Shanghai optical instrument factory, Shanghai, China), the specimens’ hardness was determined. In the studies, 100 gf of load and 15 s of loading time were the parameters employed. To lessen the experimental error, each sample was measured three times. To mitigate the impact of surface contaminants and scratches on the measurement results, the sample’s surface was ground, polished, and ultrasonically cleaned with anhydrous ethanol before the hardness test was conducted.
A universal mechanical testing equipment (Instron 68TM-30, Norwood, MA, USA) with a non-contacting video extensometer was used to conduct a room temperature tensile and compression test. Figure 3b depicts the form of the tensile specimens. The elongation gauge of the tensile and compression sample used in the experiments has a scale of about 30 mm, and the set strain rate for the experiments was 0.002/s. Triplicate specimens were prepared for each distinct structure. The tensile bars’ fractography images were detected by SEM.
2.6. Surface Modification and Characterization
2.6.1. Micro-Arc Oxidation (MAO) Process
Small cylindric samples measuring 6 mm in diameter and 4.5 mm in height (Figure 3c) with 30% RD were used for surface modification. Prior to treatment, each sample was ultrasonically cleaned for 10 min in acetone, alcohol, and deionized (DO) water. Temperatures were kept below 40 °C throughout the MAO process using the porous Ti-15Mo samples, which served as the cathode and a stainless-steel container as the anode. In this experiment, the MAO was carried out in a 10 g/L (NaPO3)6 (Sinopharm Chemical 5Reagent, Shanghai, China) basic electrolyte solution [58] with the following parameters: 450–500 V voltage, 10% duty ratio, 500 Hz pulse frequency, and 12 min oxidation time. The oxidized samples (denoted G(M) group, ISH(M) group and ISO(M) group) were then cleaned using ultrasonic vibration and distilled water for 15 min, followed by an overnight dry at 60 °C.
2.6.2. Manufacturing of Multi-Biofunctional Coating
When the introduction of bio-functionality was considered, lattice structures with better mechanical properties were selected. The antimicrobial properties were first introduced into the MAO-treated porous Ti-15Mo scaffolds. Deionized (DI) water was used for the preparation of the solution and for cleaning thoroughly. The samples were immersed in 0.05 M, 0.1 M, and 0.2 M high-concentration AgNO3 solutions [59,60], protected from light, and shaken with a magnetic stirrer for 1 h. The samples were then immersed in 10 g/L aqueous TA solution and shaken for 1 h. The samples were then removed and rinsed with DI water and sonicated for 20 min to remove the loose Ag nanoparticles and dried overnight in an oven at 55 °C.
A mixture of TA at a concentration of 30 g/L, CaCl2 at 0.5 M, and NH4F at (1/18) M [61] was prepared and heated to 90 °C. The corresponding amount of Na3PO4 at a concentration of (1/3) M was quickly added to the mixture solution and magnetically stirred. Each sample with reduced Ag nanoparticles on the surface was suspended and soaked in the middle of the solution with a thin wire for 10 h of constant temperature cross-linking reaction. The samples were then removed and rinsed with deionized water, sonicated, and dried overnight in an oven at 55 °C.
A summary of the experimental methods of surface modification is shown in Figure 2b. Since the Ag loading was the only variable in the coating for all the scaffolds, the subsequent sets of samples were named accordingly, e.g., ISH0.05, ISH0.1, and ISH0.2. The names of samples with a complete coating remained unchanged.
2.6.3. Surface Characterization
The morphology of the multi-biofunctional coating was observed by SEM, and the elemental composition and distribution were detected and analyzed by SEM-EDS. By using an auto scratch coating tester (WS-2005, Zhongke Kaihua, Dongguan, China), the coatings underwent scratch testing, and their adhesion force to substrates was assessed. The load applied by the tester was set from 0.2 N to 16 N at a loading speed of 3 N/min and a scratching speed of 3 mm/min [61,62].
2.7. Bio-Property Test: In Vitro Test
2.7.1. Cytotoxicity Test and Ion Precipitation Analysis
The samples were immersed in acetone, alcohol with a 95% alcohol concentration, and DI water for 10 min ultrasonically. The samples were dried before being sanitized for later use at a high temperature and pressure.
Preparation of leachate: Each sterilized sample was immersed in 2 mL of serum-containing cell culture medium with sodium alginate spheres. The samples were extracted at 37 °C for 24, 48, and 72 h. The leaching solutions were obtained by removing the samples.
Cytotoxicity assay: MG-63 cells were prepared into a cell suspension at a concentration of 5 × 104 cells/mL, inoculated into 96-well culture plates at 200 μL per well, and cultured in an incubator. When the cells grew to 80% confluence, different sample leachates (experimental group), sodium alginate sphere leachates (negative control), 6.4% phenol (positive control), and normal culture medium (blank control) were added sequentially. 5 replicates were set up for each group and incubated for 24 h. The number of cells in each well was determined by absorbance (OD) on a microplate reader at 450 nm. Cell viability was characterized by cell relative growth rate (RGR, Equation (4) [63]).
Ion precipitation analysis: Quantitative determination of ion precipitation by inductively coupled plasma mass spectrometry (ICP-MS). The 7700 Series ICP-MS (Agilent, Lexington, MA, USA) was turned on with Ar gas. After tuning, the mixed standard solutions were drawn, and the standard curves were made with the elements Ti, Mo, and Ag in the standard sample. The nitrified leaching solutions and blank control solution were drawn one by one, and the content of each element was determined by the full quantitative method. Finally, the element concentrations of Ti, Mo, and Ag in each leachate were calculated according to the standard curves.
2.7.2. Hemocompatibility Tests
Each experimental group of G0.05-ISH0.2, the negative control group without a sample, and the positive control group using distilled water were kept in a 24-well plate at a constant temperature at 37 °C. A fresh mouse eyeball blood solution containing 3.8% sodium citrate diluted with normal saline at a ratio of 1:5 was added to each well and incubated at 37 °C for 1 h. After the liquid was centrifuged, the OD of the supernatant was detected at a wavelength of 545 nm. Hemocompatibility was characterized as Equation (5) [64]:
2.7.3. Total Antioxidant Capacity Test
Due to the presence of TA, the antioxidative capacity of the coated samples was determined by a total antioxidant capacity assay kit (BEYOTIME, Haimen, China) with the ferric reducing ability of plasma (FRAP) method [65]. The kit is based on the principle that under acidic conditions, the antioxidants reduce Fe3+-tripyridyltriazine (TPTZ) to produce a blue Fe2+-TPTZ, which is then measured at 593 nm using a microplate reader to obtain the total antioxidant capacity of the sample. The antioxidant capacity of Trolox, a positive control with similar antioxidant capacity to that of vitamin E, was used as a benchmark for calibration. Each sample was incubated with FRAP reagent for 15–90 min at 37 °C.
2.7.4. Antibacterial Test
As a semi-quantitative assay, the inhibition zone test was utilized to assess the antimicrobial effect of the multi-coatings against Escherichia coli (E. coli) and Staphylococcus aureus (S. aureus). Both the experimental group containing the coating and the control group treated with MAO only were autoclaved. Chilled dormant E. coli and S. aureus were activated to obtain bacterial suspensions, and 100 μL of each was pipetted onto plates poured with cooled sterile solid LB medium. The bacterial suspensions were spread evenly with a spreader. Each sample was sterilized again with an alcohol lamp and pressed firmly to embed in the agar in the center of one plate. A camera was used to capture digital pictures of the samples after the plates had been removed from an incubator where they had been incubated for 24 h at 37 °C. The size of the zone was then measured.
A summary of the experimental methods of in vitro biocompatibility and the biomedical function tests is shown in Figure 2c.
2.8. Statistical Analysis
All data were analyzed by one-way ANOVA using SPSS 17.0 software (SPSS, Chicago, IL, USA) and presented as average ± standard deviation. Experiments were performed in triplicate with statistical values indicated in relevant analyses. Statistical significance was set at p < 0.05.
3. Results and Discussion
3.1. Results and Discussion of the As-Printed Dense and Porous Ti-15Mo
Under the parameters of VED = 100 J/mm3, PL = 200 W, vs = 400 mm/s, hs = 100 μm, and tl = 50 μm, dense Ti-15Mo alloy was printed with a result of 99.29% RD. Figure 4a,b gives an example of the microstructure morphology of dense samples printed with pre-alloyed Ti-15Mo powder by OM. The average melt channel width of 117.0 μm can be measured from the channels showing the full width in Figure 4a. The defects in the fusion channels and micro poles resulting from the laser scan are visible in the figure, as are the grain boundaries in the martensite and β phases after deep etching.
Figure 4.
Images of a polished and etched dense Ti-15Mo sample by OM. (a) Powder melting/laser scan path shown as uniform vertical streaks; (b) Most of the β-phase with very little of the needle-like martensite present; images of the SE mode of the SEM and results of EDS of the etched (c) as-printed and (d) as-casted dense Ti-15Mo samples; EDS spectrum of (e) as-printed and (f) as-casted dense Ti-15Mo samples, respectively.
Figure 4c,d give an example of the surface morphology and compositions of a dense sample printed with pre-alloyed Ti-15Mo powder and an as-casted sample as a control group by the SEM SE mode. The large grain boundaries of the as-cast sample are very evident when comparing the moderately etched as-printed and as-cast samples under the SE of the SEM. The EDS results show that the elemental composition of the sample is indeed 85 wt% Ti and 15 wt% Mo.
For the dense samples, tensile tests were carried out, and the results are shown in Table 1 along with others. The PBF-LB laser gave a large increase in hardness to the alloy and maintained a high level of strength while keeping the modulus low and the elongation ideal. The numbers in parentheses are standard deviations.
Table 1.
Mechanical properties of dense Ti-15Mo with and without heat treatment. compared with the literature.
Regarding the porous samples, their SEM images are shown in Figure 3d. The obtained 300–550 μm pores are favorable for cell growth. A major problem with the preparation of porous structures from metal powders by PBF-LB is that partially molten powder is on the lattice surface, making the scaffold morphology less smooth, and a morphology similar to spheroidization appears. For the purpose of in vivo bone defect applications, physical treatment such as sandblasting cannot be used to treat the surface at a cell size of 1.5 mm. The reason for using only prolonged ultrasound to remove the loose powder and not acid etching or electrolytic polishing to give the scaffold a smooth appearance is that our previous studies [69] have demonstrated to a certain extent that the metal powder in this case does not have a significant negative effect in vivo. Methods such as acid etching are more suitable for porous structures with larger cell sizes, i.e., thicker struts and larger pores. Therefore, on balance, a smaller unit cell with a simpler initial surface treatment is a more desirable combination.
The results of the XRD analysis of powder stock, as-printed scaffolds, and as-cast alloy are shown in Figure 5a. Only the β phase was detected in the interval 30–80°, with the highest peaks occurring on the β crystal plane. This indicates that the martensite content is below the XRD detection limit, which can demonstrate the phase composition of the as-printed scaffolds. In the presence of a large amount of β-phase stabilizing element Mo, the transformation of the β-phase into the α-phase is suppressed in the melting pool with a fast cooling rate, and only a small amount of the β-phase is transformed into a supersaturated solid solution (martensite) of the same composition but with a different crystal structure. This martensitic phase transformation is a diffusion-free phase transformation in which no atomic diffusion takes place; only lattice reconstruction occurs [70].
Figure 5.
(a) XRD and (b–f) EBSD results of as-printed and as-cast Ti-15Mo. (a) Indicates the grain size distribution. (c,d) EBSD mappings illustrate the as-printed samples have smaller grains. (e,f) EBSD KAM figures demonstrate very low internal stress found in the as-printed sample, though higher than that of the as-cast sample.
The results of the EBSD analysis of the as-printed scaffolds and as-cast alloy are shown in Figure 5b–f. As can be seen from Figure 5b, the as-printed scaffolds exhibited fine polycrystalline microstructures with grain sizes significantly smaller than those of the as-cast alloy. The average particle size of the former was about 40 μm, while that of the latter was about 100 μm, which was also consistent with the mapping results of Figure 5c,d. This phenomenon is due to the extremely short existence time of each melting pool of the PBF-LB technique, which effectively refines the Ti-15Mo alloy grains. The kernel average misorientation (KAM) results are shown in Figure 5e,f. The method is based on the deviation of the orientation gradients between pixels and therefore corresponds to the geometric dislocation density and local residual stresses for assessing the stress state inside a metallic material. As the results showed very low orientation gradients, only 40% of the standard color scale bar in the range 0–5 was used here for display purposes. The as-cast sample had almost no dislocations, while the as-printed Ti-15Mo showed yellow-red aggregations at the low-angle grain boundaries, indicating relatively high residual stresses in these areas.
The results of the compression and tensile tests on the as-printed porous Ti-15Mo samples are summarized in Table 2 and Table 3. Figure 6 shows the results of the compression tests on the three TPMS lattices with different RD values. The yield strength σ0.2 ranged from 78 to 130 MPa, and Young’s modulus ranged from 16 to 48 GPa for all experimental samples. Figure 6d–f show that the yield strength and Young’s modulus of TPMS lattices increase with increasing RD. Comparing the three groups with the same structural parameters and different TPMS, such as G35, ISH35, and ISO35, the Young’s modulus and yield strength are different, indicating that the different structures have a significant effect on the mechanical properties, given the same structural parameters.
Table 2.
Tensile tests results of as-printed Ti-15Mo of G, ISH, and ISO structures.
Table 3.
Compression tests results of as-printed Ti-15Mo of G, ISH, and ISO structures (with 30%, 35%, and 40% RD).
Figure 6.
Compression stress–strain curve, yield strength, and corresponding Young’s modulus of (a,d) G, (b,e), ISH, and (c,f), ISO structures.
Furthermore, the data in Table 2 and Table 3 show that the elongation of the porous structures remained relatively constant in the tensile and compression tests, but there was some degree of difference in Young’s modulus and yield strength. Considering that porous implants are mainly subjected to compressive stresses in vivo, the relatively low-strength structure of ISO will be removed from subsequent in vitro experiments and used as a control group. The mechanical properties of the G structure are slightly stronger than those of the ISH. The strut thicknesses of 0.15 mm and 0.11 mm for G30 and ISH30, respectively, are also consistent with the results of the mechanical properties analyzed in the literature [71,72], i.e., the mechanical properties are stronger with a wider support structure in the load direction, all other things being equal.
Figure 7 shows the tensile test results for the three TPMS lattices with different RD values. All flat tensile specimens show similar mechanical behavior trends to the compression specimens, with yield strengths ranging from 131 to 300 MPa and Young’s modulus ranging from 12 to 36 GPa. Figure 7g–i show the fracture analysis of three sets of tensile specimens, where the joint appearance of the cleavage planes and dimples demonstrates that all three tensile failure mechanisms were a mixture of brittle and ductile fracture.
Figure 7.
Tensile stress–strain curve, yield strength, and the corresponding Young’s modulus corresponding fractography images of (a,d,g) G, (b,e,h), ISH, and (c,f,i), ISO structures. The figures inserted are the corresponding tensile bars. (In the fractography images, green arrows point to cleavage planes of brittle fractures, and yellow arrows point to dimples of ductile fractures).
3.2. Results and Discussion of the Surface Modification of Ti-15Mo Lattices
Figure 8 represents the initial stages of surface modification. All samples designed for in vitro tests were treated by MAO and named as G(M), ISH(M), and ISO(M), respectively. The 0.1–1 μm holes were evenly distributed and tightly covered on the substrate scaffold. The composite structure of the 100-micron-scale macropore substrate scaffold and the micron-scale ceramic coating laid a foundation for the subsequent attachment of multi-biofunctional coatings with stable thermodynamic properties, larger surface area, and easier adhesion. Based on the experimental results of the mechanical properties, G(M) and ISH(M) were selected as the experimental group, and ISO(M) was henceforth set as the control group. The SEM image of the reduced Ag particles is shown in Figure 8a. The smallest individual Ag particle size was about 20 nm, with some Ag particles agglomerated up to 400 nm. Nano Ag particles were distributed evenly inside and outside the micron-scale TiO2 pores. Figure 8c,d show the EDS results for the corresponding color star symbols in Figure 8a, where the Cl peak was derived from the electrolyte of MAO. The bright white particles in the SEM were thus confirmed to be all nano Ag and attached to the microporous TiO2.
Figure 8.
(a) The reduced Ag nanoparticles are attached to the (b) TiO2 porous surface by MAO; (c,d) show the EDS results of the Ag nanoparticle and TiO2 coating from (a) respectively. The blue markings in (a) represent nano Ag. and the green ones represent the microporous TiO2 ceramic layer. The blue asterisks and arrows in (a) represent nano Ag, and the green asterisks and arrows represent the microporous TiO2 ceramic layer.
Figure 9 shows the (F)HA-TA-Ag-TiO2 coating after completion of the surface modification steps. Figure 9a shows flake HA covering the outside and inside of micron-scale TiO2 pores, while Figure 9b shows another kind of rough surface spherical HA aggregated morphology, both with a tiny amount of uncovered nano Ag. Figure 9c,d add the Ca and P peaks representing HA and the weak peak of the reactant Na based on the previous EDS. Figure 9e–g show the evidence of all the results of surface modification. TiO2, nano Ag, and HA have been distributed as the corresponding element mappings. According to Figure S1, the MAO coating was composed of an amorphous phase, whose amorphous bulge was at 20–30° in the results of GISAXS. An XRD peak corresponded to the hydroxyapatite (HA) phase at 2θ = 25.36°. These results align with the SEM observations and theoretical expectations for hydrothermal crystallization behavior [58].
Figure 9.
(a) Morphology of final (F)HA-TA-Ag-TiO2 coatings with HA (multi)crystals covered. (c,d) Show the curves of the EDS results at the corresponding marked positions in the SEM image of (b), respectively. (e) SEM image of rare one area with all three materials giving evidence of all the results of surface modification. (g) Is an EDS mapping of the SEM image of (f) based on the detection of Ti, Mo, O, Ag, Ca, and P elements.
The change of the tangential friction force was measured by the acoustic emission method to determine the bonding force between the coating and the substrate. The indenter gradually increased the pressure on the surface. When the relative displacement of the coating and the substrate occurred, an acoustic signal would be generated, as shown in Figure 10. When the coating failed, there would be acoustic feedback, and the corresponding normal critical load (Lc) was used to characterize the bonding force between the film and the substrate. The larger the critical load, the stronger the bonding between the coating and the substrate. The average binding force (Lc) of TiO2 prepared by MAO was ~30N, and the average bonding force between the complete coating and the substrate was 9.98 N, which is comparable to the conclusions of some existing literature [61]. The data indicate that MAO can indeed prepare a well-bonded ceramic layer; the bonding force of the composite coating is greater than the literature reference value of ~6.5 N for HA, also indicating the advantage of F-doping on the stability of the outermost HA layer.
Figure 10.
The results of bonding strength between functional (F)HA-TA-Ag-TiO2 coatings and the substrate were recorded by the auto scratch coating tester. Lc = 9.98 ± 3.43 N.
3.3. Results and Discussion of the In Vitro Analysis of Coated Ti-15Mo Scaffolds
When testing the biologically relevant properties of coated porous Ti-15Mo, the experimental groups involved were G and ISH samples treated with all surface modification steps (i.e., G0.05 to ISH0.2), and the control group was mainly the MAO-treated ISO(M) only. The ion release amounts of Ti, Mo, and Ag from the leachates for 0–24 h, 24–48 h, and 48–72 h for each group of samples were calculated and are presented in the histograms in Figure 11. The ionic release of Ti and Mo was minimal for all groups of samples, and no Ag was detected for ISO(M), as no Ag was added. For each experimental group, the line graph in Figure 11c systematically reflects the overall precipitation of Ag from the coating over the three days, with a steady increase in the amount released. This demonstrates not only the feasibility of releasing the effective ions from the coating in the incubation environment, but also the slow release effect. The minimum total Ag release was about 13.5 μg, and the G0.05 and ISH0.05 groups released about 18.5 μg and 17 μg, respectively, which is high compared to the literature results of several micrograms [59,73].
Figure 11.
(a) Ti, (b) Mo, and (c) Ag ion precipitation results of the leaching solution obtained after co-incubation with each group of samples for 24, 48, and 72 h, respectively, measured by ICP-MS. The line graph of cumulative ion precipitation of Ag shows the continuous release of Ag from the coating over 72 h.
Figure 12 shows the results of cell and blood compatibility. As Ti-15Mo and TiO2 have not been shown to be antibacterial and cytotoxic, the 94.2% RGR result of the control group ISO(M) allowed for a rough estimate of the cell proliferative effect of MAO-treated as-printed Ti-15Mo lattices. The cytotoxicity results showed that the RGR of each experimental group was higher than 94.2%, indicating that the high Ag ion release concentration and the TiO2 ceramic layer of the composite coating were non-toxic to cells, and the overall cytocompatibility of the composite coating was better than that of microporous TiO2. In the hemolysis assay, the sample was in direct contact with the blood cells, and hemolysis is related to osmotic pressure and hemoglobin degeneration caused by ions. As can be seen from Figure 12b, G0.1 had the highest hemolysis rate, followed by G0.2 and ISH0.1, all of which were higher than the 5% hemolysis safety line. ISH0.2 had a relatively low hemolysis rate, but still reached 3.498% and should not be preferred. G0.05 and ISH0.05 reflected ideal safety.
Figure 12.
(a) Cell viability (RGR%) at 72 h and (b) the hemolysis ratio of the samples.
After the comprehensive ion precipitation, cytocompatibility, and hemocompatibility tests results, G0.05 and ISH0.05 were selected for superiority. The two groups of samples with AgNO3 concentration of 0.1 M at the time of preparation showed the highest Ag concentration in both ion release and hemocompatibility assays, while G0.2 and ISH0.2 did not show the most significant toxicity. The reason for such results may be that at high Ag levels, the Ag ion in the leaching solution reaches an appropriate amount to bind to proteins such as serum in the medium, and hemoglobin is directly bound by the excess Ag in the sample, in order to form a stable precipitate without exerting significant toxicity.
The results of antioxidant properties are shown in Figure 13. Figure 13a shows that the absorbance values used to measure the total antioxidant capacity to ROS of the (F)HA-TA-Ag-TiO2 coating in G0.05 and ISH0.05 gradually increase with incubation time, due to the slow sustained release of TA from the coating. Therefore, the prepared (F)HA-TA-Ag-TiO2 coating has long-term anti-oxidation properties. The antioxidant capacity of the coatings with different TPMS structures was found to be similar, further indicating that the antioxidant properties of the composite coatings are conferred by the TA.
Figure 13.
(a) Diagram of the antioxidant mechanism of TA [74,75]. (b) The total antioxidant capacity of G0.05 and ISH0.05 compared with Trolox for 15–90 min. (c) The total antioxidant capacity of G0.05 and ISH0.05 compared with control groups at 90 min.
The antibacterial test results of the samples are shown in Figure 14. As a semi-quantitative test, the size of the inhibition zone is summarized in Table 4. The inhibition zone pattern of the ISH0.05 group was complete, the size was relatively larger, and the higher silver ion release radius showed better antibacterial performance. In contrast, the G0.05 group also had a good performance of the inhibition zone, but the edge of the zone was not smooth, and the size was relatively small. The control group had no bactericidal properties because it lacked Ag. The results reflect that different TPMS structures affect the amount of Ag released, with almost a twofold difference in the radial length of the corresponding inhibition circles.
Figure 14.
G0.05, ISH0.05, and control ISO(M) results for S. aureus and E. coli inhibition circles. The lower left triangular division of each Petri dish photograph shows the clearer inhibition effect after the removal of the corresponding sample at the end of the experiment.
Table 4.
Results of the inhibition zones (expressed in millimeters).
When the structural parameters are the same, it means that the same amount of pre-alloyed powder is used. At this time, it can be assumed that the larger the surface area, the smaller/thinner the struts of the lattice. In order to explain the gap of doubling the antimicrobial capacity of ISH0.05 versus G0.05, the surface area of two CAD models with the same structural parameters, G30 and ISH30, was analyzed using Python 3.8.8 to obtain a result of 542.98 mm2 for G30 and 629.33 mm2 for ISH30, consistent with the previous results for the thickness of struts. With similar ion precipitation results, a difference in surface area of approximately 16% may not be sufficient to determine the antimicrobial efficiency gap alone, so the pore structure of the ISH structure may be more favorable to the coating of the active ingredient for bactericidal applications.
4. Conclusions
In this work, porous β-phase Ti-15Mo TPMS alloys based on Gyroid, I-WP Sheet, and I-WP solid lattices were fabricated by PBF-LB. The unit cell size was 1.5 mm, the relative density (RD) was 30–40%, the compressive modulus was 16–48 GPa, and the yield strength σ0.2 ranged from 78 to 130 MPa, which was effectively close to the mechanical parameters of human bone. After using MAO to prepare functional modification layers, the antibacterial, antioxidative and osteopromoting composite coatings were successfully prepared by using broad-spectrum antibacterial Ag, antioxidative tannic acid and (F)HA with high stability, respectively. It was demonstrated that the G and ISH groups, with an Ag ion release of about 6 μg/D and an RD of 30% possessed better antioxidant and biocompatible properties, with the ISH group having better antibacterial ability. For the same structural parameters, ISH lattices have somewhat weaker mechanical properties than G lattices and are more biofunctional with the multi-coatings.
Supplementary Materials
The following supporting information can be downloaded at: https://www.mdpi.com/article/10.3390/met15040355/s1, Figure S1: (a) Grazing incidence small-angle X-ray scattering patterns of final (F)HA-TA-Ag-TiO2 coatings. (b) XRD results of (F) HA-TA-Ag-TiO2 coatings.
Author Contributions
Conceptualization, Z.S.; Methodology, Z.L. and J.X.; Software, J.X.; Validation, Z.L. and J.T.; Investigation, Z.L. and J.X.; Resources, J.T. and Z.S.; Data curation, Z.L. and J.T.; Writing—original draft, Z.L. and J.X.; Writing—review & editing, J.T. and M.Y.; Visualization, J.X.; Supervision, Z.S. and M.Y.; Project administration, M.Y. All authors have read and agreed to the published version of the manuscript.
Funding
This work is supported by the Key Research and Development Program of Jiangsu Province (K22251901), the National Natural Science Foundation of China (52271032), and the Shenzhen Science and Technology Innovation Commission (JCYJ20220818100612027).
Data Availability Statement
The original contributions presented in the study are included in the article/Supplementary Materials, further inquiries can be directed to the corresponding authors.
Acknowledgments
The authors would also like to acknowledge the technical support from SUSTech CRF.
Conflicts of Interest
The authors declare no conflict of interest.
References
- ASTM F67-13; Standard Specification for Unalloyed Titanium for Surgical Implant Applications. American society for Testing and Materials: Philadelphia, PA, USA, 2017.
- Li, Y.; Wang, F. Review of 3D-Printed Titanium-Based Implants: Materials and Post-Processing. ChemBioEng Rev. 2024, 11, e202400032. [Google Scholar] [CrossRef]
- Xu, J.; Zhang, J.; Shi, Y.; Tang, J.; Huang, D.; Yan, M.; Dargusch, M.S. Surface Modification of Biomedical Ti and Ti Alloys: A Review on Current Advances. Materials 2022, 15, 1749. [Google Scholar] [CrossRef] [PubMed]
- Mesa-Restrepo, A.; Byers, E.; Brown, J.L.; Ramirez, J.; Allain, J.P.; Posada, V.M. Osteointegration of Ti Bone Implants: A Study on How Surface Parameters Control the Foreign Body Response. ACS Biomater. Sci. Eng. 2024, 10, 4662–4681. [Google Scholar] [CrossRef] [PubMed]
- Raja, P.; Babu, K.B.; Kannan, R.; Shanmugam, V.; Balaji, N.S.; Sahani, R.; Behera, L.; Pugazhenthi, A.; Thansekhar, M.R. Progress in the Optimization of Compositional Design and Thermomechanical Processing of Metastable β Ti Alloys for Biomedical Applications. ACS Biomater. Sci. Eng. 2024, 10, 3528–3547. [Google Scholar] [CrossRef]
- Yan, M.; Qian, M.; Kong, C.; Dargusch, M. Impacts of trace carbon on the microstructure of as-sintered biomedical Ti-15Mo alloy and reassessment of the maximum carbon limit. Acta Biomater. 2014, 10, 1014–1023. [Google Scholar] [CrossRef]
- Geetha, M.; Singh, A.K.; Asokamani, R.; Gogia, A.K. Ti based biomaterials, the ultimate choice for orthopaedic implants—A review. Prog. Mater. Sci. 2009, 54, 397–425. [Google Scholar] [CrossRef]
- dos Santos, M.L.; Riccardi, C.d.S.; Filho, E.d.A.; Guastaldi, A.C. Calcium phosphates of biological importance based coatings deposited on Ti-15Mo alloy modified by laser beam irradiation for dental and orthopedic applications. Ceram. Int. 2018, 44, 22432–22438. [Google Scholar] [CrossRef]
- Pronina, Y.; Narykova, M.; Kachanov, M. Relating Stiffness Changes in Porous Materials to the Evolution of Pore Space. Mech. Mater. 2025, 202, 105236. [Google Scholar] [CrossRef]
- Li, Z.; Mo, H.; Tian, J.; Li, J.; Xia, S.; Jia, X.; Zhou, L.; Lu, Y. Compressive Properties and Fracture Behaviours of Ti/Al Interpenetrating Phase Composites with Additive-Manufactured Triply Periodic Minimal Surface Porous Structures. Met. Mater. Int. 2024, 31, 955–970. [Google Scholar] [CrossRef]
- Bram, M.; Stiller, C.; Buchkremer, H.P.; Stöver, D.; Baur, H. High-porosity titanium, stainless steel, and superalloy parts. Adv. Eng. Mater. 2000, 2, 196–199. [Google Scholar] [CrossRef]
- Guo, C.; Ding, T.; Cheng, Y.; Zheng, J.; Fang, X.; Feng, Z. The Rational Design, Biofunctionalization and Biological Properties of Orthopedic Porous Titanium Implants: A Review. Front. Bioeng. Biotechnol. 2025, 13, 1548675. [Google Scholar] [CrossRef]
- Chang, S.Y.; Kang, D.H.; Cho, S.K. Innovative Developments in Lumbar Interbody Cage Materials and Design: A Comprehensive Narrative Review. Asian Spine J. 2024, 18, 444–457. [Google Scholar] [CrossRef] [PubMed]
- Karageorgiou, V.; Kaplan, D. Porosity of 3D biomaterial scaffolds and osteogenesis. Biomaterials 2005, 26, 5474–5491. [Google Scholar] [CrossRef]
- Balla, V.K.; Bodhak, S.; Bose, S.; Bandyopadhyay, A. Porous tantalum structures for bone implants: Fabrication, mechanical and in vitro biological properties. Acta Biomater. 2010, 6, 3349–3359. [Google Scholar] [CrossRef]
- Cwieka, K.; Wysocki, B.; Skibinski, J.; Chmielewska, A.; Swieszkowski, W. Numerical Design of Open-Porous Titanium Scaffolds for Powder Bed Fusion Using Laser Beam (PBF-LB). J. Mech. Behav. Biomed. Mater. 2023, 151, 106359. [Google Scholar] [CrossRef]
- Mohsan, A.U.H.; Wei, D. Advancements in Additive Manufacturing of Tantalum via the Laser Powder Bed Fusion (PBF-LB/M): A Comprehensive Review. Materials 2023, 16, 6419. [Google Scholar] [CrossRef]
- Tang, J.; Li, S.; Liu, Y.; Pei, G.; Yan, M. Significantly Enhanced Biocompatibility and Performance of 3D-Printed Porous 316L Stainless Steel via a Simple and Efficient Surface Polishing Approach. Mater. Des. 2025, 251, 113640. [Google Scholar] [CrossRef]
- Liu, H.; Chen, H.; Sun, B.; Fan, D.; Zhang, A.; Liu, H.; Wei, H.; Yang, W.; Li, Y.; Xia, P.; et al. Enhancing Angiogenesis and Osseointegration through a Double Gyroid Ti6Al4V Scaffold with Triply Periodic Minimal Surface. Bio. Design Manuf. 2024, 8, 36–54. [Google Scholar] [CrossRef]
- Lai, R.; Jiang, J.; Huo, Y.; Wang, H.; Bosiakov, S.; Lyu, Y.; Li, L. Design of Novel Graded Bone Scaffolds Based on Triply Periodic Minimal Surfaces with Multi-Functional Pores. Front. Bioeng. Biotechnol. 2025, 13, 1503582. [Google Scholar] [CrossRef]
- Bidan, C.M.; Wang, F.M.; Dunlop, J.W. Dunlop, A three-dimensional model for tissue deposition on complex surfaces. Comput. Methods Biomech. 2013, 16, 1056–1070. [Google Scholar] [CrossRef]
- Jinnai, H.; Watashiba, H.; Kajihara, T.; Nishikawa, Y.; Takahashi, M.; Ito, M. Surface curvatures of trabecular bone microarchitecture. Bone 2002, 30, 191–194. [Google Scholar] [CrossRef]
- Pinkall, U.; Polthier, K. Computing Discrete Minimal Surfaces and Their Conjugates. Exp. Math. 1993, 2, 15–36. [Google Scholar] [CrossRef]
- Çalışkan, C.İ.; Şahin, M.; Koca, A.; Tarakçı, G.; Okbaz, A.; Dalkılıç, A.S. Mechanical Performance and ANN-Based Prediction of Co-Cr Dental Alloys with Gyroid Cellular Structures Produced by LPBF Technology. Proc. Inst. Mech. Eng. Part C J. Mech. Eng. Sci. 2025, 1–19. [Google Scholar] [CrossRef]
- Zou, S.; Gong, H.; Gao, J. Additively Manufactured Multilevel Voronoi-Lattice Scaffolds with Bonelike Mechanical Properties. ACS Biomater. Sci. Eng. 2022, 8, 3022–3037. [Google Scholar] [CrossRef]
- Afshar, M.; Anaraki, A.P.; Montazerian, H.; Kadkhodapour, J. Additive manufacturing and mechanical characterization of graded porosity scaffolds designed based on triply periodic minimal surface architectures. J. Mech. Behav. Biomed. Mater. 2016, 62, 481–494. [Google Scholar] [CrossRef]
- Simske, S.; Ayers, R.; Bateman, T. Porous materials for bone engineering. Mater. Sci. Forum 1997, 250, 151–182. [Google Scholar] [CrossRef]
- Klenke, F.M.; Liu, Y.; Yuan, H.; Hunziker, E.B.; Siebenrock, K.A.; Hofstetter, W. Impact of pore size on the vascularization and osseointegration of ceramic bone substitutes in vivo. J. Biomed. Mater. Res. Part A 2008, 85A, 777–786. [Google Scholar] [CrossRef]
- Murphy, C.M.; Haugh, M.G.; O’Brien, F.J. The effect of mean pore size on cell attachment, proliferation and migration in collagen-glycosaminoglycan scaffolds for bone tissue engineering. Biomaterials 2010, 31, 461–466. [Google Scholar] [CrossRef]
- Hollister, S.; Lin, C.; Saito, E.; Schek, R.; Taboas, J.; Williams, J.; Partee, B.; Flanagan, C.; Diggs, A.; Wilke, E.; et al. Engineering craniofacial scaffolds. Orthod. Craniofacial Res. 2005, 8, 162–173. [Google Scholar] [CrossRef] [PubMed]
- Kumar, A.; Webster, T.J.; Biswas, K.; Basu, B. Flow cytometry analysis of human fetal osteoblast fate processes on spark plasma sintered hydroxyapatite-titanium biocomposites. J. Biomed. Mater. Res. Part A 2013, 101, 2925–2938. [Google Scholar] [CrossRef]
- Gnilitskyi, I.; Dolgov, L.; Tamm, A.; Ferraria, A.M.; Diedkova, K.; Kopanchuk, S.; Tsekhmister, Y.; Veiksina, S.; Polewczyk, V.; Pogorielov, M. Enhanced Osteointegration and Osteogenesis of Osteoblast Cells by Laser-Induced Surface Modification of Ti Implants. Nanomed. Nanotechnol. Biol. Med. 2024, 62, 102785. [Google Scholar] [CrossRef]
- Sun, X.D.; Liu, T.T.; Wang, Q.Q.; Zhang, J.; Cao, M.S. Surface Modification and Functionalities for Titanium Dental Implants. ACS Biomater. Sci. Eng. 2023, 9, 4442–4461. [Google Scholar] [CrossRef]
- Costa Filho, P.M.D.; Marcantonio, C.C.; de Oliveira, D.P.; Lopes, M.E.S.; Puetate, J.C.S.; Faria, L.V.; Carvalho, L.d.F.; de Molon, R.S.; Junior, I.R.G.; Nogueira, A.V.B.; et al. Titanium Micro-Nano Textured Surface with Strontium Incorporation Improves Osseointegration: An In Vivo and In Vitro Study. J. Appl. Oral Sci. 2024, 32, e20240144. [Google Scholar] [CrossRef]
- Robertson, S.F.; Bandyopadhyay, A.; Bose, S. Titania nanotube interface to increase adhesion strength of hydroxyapatite sol-gel coatings on Ti-6Al-4V for orthopedic applications. Surf. Coatings Technol. 2019, 372, 140–147. [Google Scholar] [CrossRef]
- Li, G.; Ma, F.; Liu, P.; Qi, S.; Li, W.; Zhang, K.; Chen, X. Review of Micro-Arc Oxidation of Titanium Alloys: Mechanism, Properties and Applications. J. Alloys Compd. 2023, 948, 169773. [Google Scholar] [CrossRef]
- Verdier, S.; Boinet, M.; Maximovitch, S.; Dalard, F. Formation, structure and composition of anodic films on AM60 magnesium alloy obtained by DC plasma anodizing. Corros. Sci. 2005, 47, 1429–1444. [Google Scholar] [CrossRef]
- Dittrich, K.; Krysmann, W.; Kurze, P.; Schneider, H.G. Structure and Properties of Anof Layers. Cryst. Res. Technol. 1984, 19, 93–99. [Google Scholar] [CrossRef]
- Liu, X.Y.; Chu, P.K.; Ding, C.X. Surface modification of titanium, titanium alloys, and related materials for biomedical applications. Mater. Sci. Eng. R Rep. 2004, 47, 49–121. [Google Scholar] [CrossRef]
- Ma, C.F.; Li, D.M.; Jiang, B.L.; Li, H.J. Study on surface bio-modification of titanium implant using microarc oxidation technology. J. Fourth Mil. Med. Univ. 2004, 25, 4–7. [Google Scholar]
- Gross, K.A.; Rodríguez-Lorenzo, L.M. Sintered hydroxyfluorapatites. Part 1: Sintering ability of precipitated solid solution powders. Biomaterials 2004, 25, 1375–1384. [Google Scholar] [CrossRef]
- Gross, K.A.; Rodríguez-Lorenzo, L.M. Sintered hydroxyfluorapatites. Part II: Mechanical properties of solid solutions determined by microindentation. Biomaterials 2004, 25, 1385–1394. [Google Scholar] [CrossRef]
- Li, B.; Zhao, P.; Liu, S.; Wang, D.; Li, H.; Liang, C.; Wang, H. Preparation and Properties of Hydroxyapatite/Chitosan Coatings on Ti Surface by Different Electrochemical Methods. J. Mater. Eng. Perform. 2024, 1–9. [Google Scholar] [CrossRef]
- Boanini, E.; Torricelli, P.; Gazzano, M.; Della Bella, E.; Fini, M.; Bigi, A. Combined effect of strontium and zoledronate on hydroxyapatite structure and bone cell responses. Biomaterials 2014, 35, 5619–5626. [Google Scholar] [CrossRef]
- Qu, H.; Wei, M. Effect of fluorine content on mechanical properties of sintered fluoridated hydroxyapatite. Mater. Sci. Eng. C 2006, 26, 46–53. [Google Scholar] [CrossRef]
- Qu, H.; Wei, M. The effect of fluoride contents in fluoridated hydroxyapatite on osteoblast behavior. Acta Biomater. 2006, 2, 113–119. [Google Scholar] [CrossRef]
- LeGeros, R.Z. Properties of osteoconductive biomaterials: Calcium phosphates. Clin. Orthop. Relat. Res. 2002, 395, 81–98. [Google Scholar] [CrossRef]
- Ratha, I.; Datta, P.; Reger, N.C.; Das, H.; Balla, V.K.; Devi, K.B.; Roy, M.; Nandi, S.K.; Kundu, B. In Vivo Osteogenesis of Plasma Sprayed Ternary-Ion Doped Hydroxyapatite Coatings on Ti6Al4V for Orthopaedic Applications. Ceram. Int. 2022, 48, 11475–11488. [Google Scholar] [CrossRef]
- Kaczmarek-Szczepańska, B.; Zasada, L.; Michalska-Sionkowska, M.; Vishnu, J.; Manivasagam, G. The Modification of Titanium Surface by Decomposition of Tannic Acid Coating. Appl. Sci. 2023, 13, 5204. [Google Scholar] [CrossRef]
- DOh, D.X.; Prajatelistia, E.; Ju, S.-W.; Kim, H.J.; Baek, S.-J.; Cha, H.J.; Jun, S.H.; Ahn, J.-S.; Hwang, D.S. A rapid, efficient, and facile solution for dental hypersensitivity: The tannin-iron complex. Sci. Rep. 2015, 5, srep10884. [Google Scholar] [CrossRef]
- Huang, D.; Lin, Q.; Yin, M.; Wei, Y.; Du, J.; Hu, Y.; Zhao, L.; Lian, X.; Chen, W. Ag nanoparticles decorated electrospinning carbon nanotubes/polyamide nanofibers. J. Biomater. Sci. Polym. Ed. 2019, 30, 1744–1755. [Google Scholar] [CrossRef]
- Al-Ketan, O.; Abu Al-Rub, R.K. MSLattice: A free software for generating uniform and graded lattices based on triply periodic minimal surfaces. Mater. Des. Process. Commun. 2021, 3, e205. [Google Scholar] [CrossRef]
- Al-Ketan, O.; Assad, M.A.; Abu Al-Rub, R.K. Mechanical properties of periodic interpenetrating phase composites with novel architected microstructures. Compos. Struct. 2017, 176, 9–19. [Google Scholar] [CrossRef]
- Al-Ketan, O.; Rowshan, R.; Abu Al-Rub, R.K. Topology-mechanical property relationship of 3D printed strut, skeletal, and sheet based periodic metallic cellular materials. Addit. Manuf. 2018, 19, 167–183. [Google Scholar] [CrossRef]
- Zhu, W.; Moumni, Z.; Zhu, J.; Zhang, Y.; Li, S.; Zhang, W. A Multi-Scale Experimental Investigation for Fatigue Limit and Fatigue Crack Initiation Behavior of Powder Bed Fusion-Laser Beam 316L Stainless Steel. Mater. Sci. Eng. A 2023, 866, 144692. [Google Scholar] [CrossRef]
- Schuh, B.; Völker, B.; Todt, J.; Schell, N.; Perrière, L.; Li, J.; Couzinié, J.; Hohenwarter, A. Thermodynamic instability of a nanocrystalline, single-phase TiZrNbHfTa alloy and its impact on the mechanical properties. Acta Mater. 2018, 142, 201–212. [Google Scholar] [CrossRef]
- Li, C.-L.; Wang, C.-S.; Narayana, P.; Hong, J.-K.; Choi, S.-W.; Kim, J.H.; Lee, S.W.; Park, C.H.; Yeom, J.-T.; Mei, Q. Formation of equiaxed grains in selective laser melted pure titanium during annealing. J. Mater. Res. Technol. 2021, 11, 301–311. [Google Scholar] [CrossRef]
- Tang, J.; Wu, Z.; Yao, X.; Zhou, Y.; Xiong, Y.; Li, Y.; Xu, J.; Dargusch, M.S.; Yan, M. From bio-inertness to osseointegration and antibacterial activity: A one-step micro-arc oxidation approach for multifunctional Ti implants fabricated by additive manufacturing. Mater. Des. 2022, 221, 110962. [Google Scholar] [CrossRef]
- Jia, Z.; Xiu, P.; Li, M.; Xu, X.; Shi, Y.; Cheng, Y.; Wei, S.; Zheng, Y.; Xi, T.; Cai, H.; et al. Bioinspired anchoring AgNPs onto micro-nanoporous TiO2 orthopedic coatings: Trap-killing of bacteria, surface-regulated osteoblast functions and host responses. Biomaterials 2016, 75, 203–222. [Google Scholar] [CrossRef]
- Huang, D.; Lin, Q.X.; Zhou, Y.J.; Li, J.X.; Wei, Y.; Hu, Y.C.; Lian, X.J.; Chen, S.; Chen, W.Y. Ag nanoparticles incorporated tannic acid/nanoapatite composite coating on Ti implant surfaces for enhancement of antibacterial and antioxidant properties. Surf. Coatings Technol. 2020, 399, 126169. [Google Scholar] [CrossRef]
- He, G.; Guo, B.; Wang, H.; Liang, C.; Ye, L.; Lin, Y.; Cai, X. Surface characterization and osteoblast response to a functionally graded hydroxyapatite/fluoro-hydroxyapatite/titanium oxide coating on titanium surface by sol-gel method. Cell Prolif. 2014, 47, 258–266. [Google Scholar] [CrossRef]
- Xu, S.; Long, J.; Sim, L.; Diong, C.H.; Ostrikov, K. RF plasma sputtering deposition of hydroxyapatite bioceramics: Synthesis, performance, and biocompatibility. Plasma Process. Polym. 2005, 2, 373–390. [Google Scholar] [CrossRef]
- Shi, R.; Huang, Y.; Zhang, J.; Wu, C.; Gong, M.; Tian, W.; Zhang, L. Effective delivery of mitomycin-C and meloxicam by double-layer electrospun membranes for the prevention of epidural adhesions. J. Biomed. Mater. Res. Part B Appl. Biomater. 2020, 108, 353–366. [Google Scholar] [CrossRef]
- Wei, Z.; Tian, P.; Liu, X.; Zhou, B. Hemocompatibility and selective cell fate of polydopamine-assisted heparinized PEO/PLLA composite coating on biodegradable AZ31 alloy. Colloids Surfaces B Biointerfaces 2014, 121, 451–460. [Google Scholar] [CrossRef]
- Benzie, I.F.F.; Strain, J.J. The ferric reducing ability of plasma (FRAP) as a measure of “antioxidant power”: The FRAP assay. Anal. Biochem. 1996, 239, 70–76. [Google Scholar] [CrossRef]
- Sugano, M.; Tsuchida, Y.; Satake, T.; Ikeda, M. A microstructural study of fatigue fracture in titanium-molybdenum alloys. Mater. Sci. Eng. A Struct. Mater. Prop. Microstruct. Process. 1998, 243, 163–168. [Google Scholar]
- Júnior, J.R.S.M.; Nogueira, R.A.; de Araújo, R.O.; Donato, T.A.G.; Arana-Chavez, V.E.; Claro, A.P.R.A.; Moraes, J.C.S.; Buzalaf, M.A.R.; Grandini, C.R. Preparation and Characterization of Ti-15Mo Alloy used as Biomaterial. Mater. Res. 2011, 14, 107–112. [Google Scholar] [CrossRef]
- Ho, W.-F. A comparison of tensile properties and corrosion behavior of cast Ti-7.5Mo with c.p. Ti, Ti-15Mo and Ti-6Al-4V alloys. J. Alloys Compd. 2008, 464, 580–583. [Google Scholar] [CrossRef]
- Tang, J.; Luo, J.; Huang, Y.; Sun, J.; Zhu, Z.; Xu, J.; Dargusch, M.; Yan, M. Immunological response triggered by metallic 3D printing powders. Addit. Manuf. 2020, 35, 101392. [Google Scholar] [CrossRef]
- Wang, C.H.; Yang, C.D.; Liu, M.; Li, X.; Hu, P.F.; Russell, A.M.; Cao, G.H. Martensitic microstructures and mechanical properties of as-quenched metastable β-type Ti–Mo alloys. J. Mater. Sci. 2016, 51, 6886–6896. [Google Scholar] [CrossRef]
- Luo, J.; Huang, Y.; Xu, J.; Sun, J.; Dargusch, M.; Hou, C.; Ren, L.; Wang, R.; Ebel, T.; Yan, M. Additively manufactured biomedical Ti-Nb-Ta-Zr lattices with tunable Young’s modulus: Mechanical property, biocompatibility, and proteomics analysis. Mater. Sci. Eng. C 2020, 114, 110903. [Google Scholar] [CrossRef]
- Cheng, H. Additive Manufacturing and Mechanical Properties of Functionally Graded Medical Ti–35Nb–7Zr–5Ta Porous Scaffolds. J. Physics Conf. Ser. 2021, 1986, 012036. [Google Scholar] [CrossRef]
- Jamuna-Thevi, K.; Bakar, S.; Ibrahim, S.; Shahab, N.; Toff, M. Quantification of silver ion release, in vitro cytotoxicity and antibacterial properties of nanostuctured Ag doped TiO2 coatings on stainless steel deposited by RF magnetron sputtering. Vacuum 2011, 86, 235–241. [Google Scholar] [CrossRef]
- Labieniec, M.; Gabryelak, T.; Falcioni, G. Antioxidant and pro-oxidant effects of tannins in digestive cells of the freshwater mussel Unio tumidus. Mutat. Res. Toxicol. Environ. Mutagen. 2003, 539, 19–28. [Google Scholar] [CrossRef]
- Parashar, U.K.; Kumar, V.; Bera, T.; Saxena, P.S.; Nath, G.; Srivastava, S.K.; Giri, R.; Srivastava, A. Study of mechanism of enhanced antibacterial activity by green synthesis of silver nanoparticles. Nanotechnology 2011, 22, 415104. [Google Scholar] [CrossRef]
Disclaimer/Publisher’s Note: The statements, opinions and data contained in all publications are solely those of the individual author(s) and contributor(s) and not of MDPI and/or the editor(s). MDPI and/or the editor(s) disclaim responsibility for any injury to people or property resulting from any ideas, methods, instructions or products referred to in the content. |
© 2025 by the authors. Licensee MDPI, Basel, Switzerland. This article is an open access article distributed under the terms and conditions of the Creative Commons Attribution (CC BY) license (https://creativecommons.org/licenses/by/4.0/).